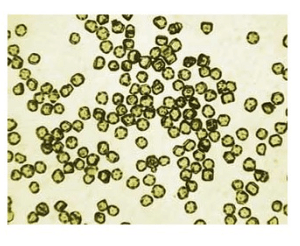
Nano Diamond Supplier in India #1 5 NanoPure-G, grade G

Nano Diamond Supplier in India #1
In the rapidly advancing field of nanotechnology, Nano Diamonds have gained significant attention due to their exceptional hardness, thermal conductivity, and biocompatibility. As industries increasingly integrate nano diamonds into their products, finding a trusted supplier is crucial. Hiyka stands out as one of the top nano diamond suppliers in India, offering high-quality nano diamonds for various industrial and research applications.

Introduction to Nano Diamonds
Nano Diamonds are ultra-small diamond particles, typically in the nanometer range, that exhibit extraordinary mechanical strength, thermal stability, and chemical resistance. These properties make them ideal for a wide range of applications, including electronics, medicine, coatings, and advanced manufacturing.
Why Choose Hiyka as Your Nano Diamond Supplier?
Hiyka has established itself as a leading supplier of nano diamonds, delivering high-quality materials to industries and research institutions. Here’s why Hiyka is the preferred choice:
High-Purity Nano Diamonds: Hiyka ensures that its nano diamonds meet the highest purity standards for demanding applications.
Wide Range of Products: Offers monocrystalline, polycrystalline, and detonation-synthesized nano diamonds.
Advanced Manufacturing Process: Utilizes cutting-edge technology to maintain consistent quality and performance.
Customization Options: Provides tailored solutions to meet specific customer needs.
Commitment to Quality: Adheres to international standards in production and quality control.
Applications of Hiyka’s Nano Diamonds
Nano Diamonds supplied by Hiyka are widely used across multiple industries, offering innovative solutions to various technological challenges. Key applications include:
Electronics & Semiconductors
Enhances thermal conductivity in high-performance electronic devices.
Used in microchips and nano-lubricants for reduced friction and wear.
Biomedical & Pharmaceutical Applications
Used in targeted drug delivery and cancer treatment research.
Plays a role in advanced medical imaging and biosensors.
Lubricants & Coatings
Improves wear resistance in industrial coatings and lubricants.
Enhances the durability of cutting tools and mechanical components.
Aerospace & Automotive Industry
Strengthens composite materials for lightweight and high-performance applications.
Used in anti-friction coatings and thermal management solutions.
Polishing & Surface Finishing
Essential for ultra-precise polishing of optical lenses and semiconductor wafers.
Enhances surface smoothness in high-end manufacturing.
Hiyka’s Commitment to Sustainability
Hiyka prioritizes sustainability in its manufacturing processes by adopting eco-friendly production techniques. The company ensures minimal environmental impact while maintaining high-quality standards for nano diamonds.
Why Indian Industries Trust Hiyka?
Hiyka has built a strong reputation in the nanotechnology sector in India. Here’s why customers prefer Hiyka for their nano diamond needs:
Cost-Effective Solutions: Competitive pricing without compromising quality.
Reliable Supply Chain: Ensures timely delivery and bulk order fulfillment.
Customer-Centric Approach: Offers technical support and expert guidance.
Continuous Innovation: Invests in R&D to develop advanced nano diamond-based solutions.
Partner with Hiyka for Cutting-Edge Nano Diamond Solutions
As industries embrace advanced materials, the demand for nano diamonds is rising. Hiyka is committed to providing the highest quality nano diamond products to meet this growing need. Whether you’re a researcher seeking high-purity nano diamonds or a manufacturer looking to enhance your products, we have the right solution for you.
Join the nano diamond revolution with Hiyka—India’s most trusted and leading supplier. Contact us today to learn more about our products and how we can help you integrate nano diamonds into your applications.
📞 Contact us today for bulk orders or custom nano diamond formulations.
Conclusion
With the growing demand for nano diamonds in various industries, selecting a reliable supplier is crucial. Hiyka is a trusted Nano Diamond Supplier in India, offering high-quality nano diamonds tailored for diverse applications. Whether you are in electronics, medicine, coatings, or aerospace, Hiyka has the right solutions for your needs.
For inquiries, bulk orders, or technical assistance, reach out to Hiyka today and take your industry to the next level with cutting-edge nanotechnology!
Showing 17–24 of 27 results
-
Sale!

Nanodiamond-nanographite mixture, purified
Original price was: ₹21,686.00.₹13,143.00Current price is: ₹13,143.00. -
Sale!

Graphite / Diamond Nanomixture (most native, raw, just after explosion)
Original price was: ₹12,865.00.₹7,797.00Current price is: ₹7,797.00. -

Nano Diamonds Extra-pure
-

NanoPure-G01 ,grade G01
-

Nano Diamonds, NanoPure-G, grade G
-

Nano Diamonds, Purified, Grade G01
-
Sale!

Diamond Particles: From Sub-Micron to Micron
Original price was: ₹8,821.00.₹5,346.00Current price is: ₹5,346.00. -

Single-Digit NanoDiamonds (SDND)
📞 Contact us today for bulk orders or custom Nano Diamonds formulations